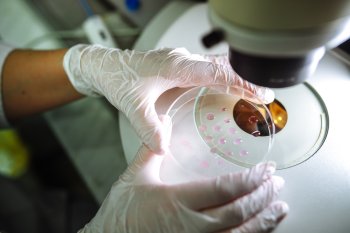

STIRI . ARTICOLE . loto
Cu câți bani a rămas românul care a câștigat 13 milioane de euro la Joker, după impozit
S-a dat cel mai mare premiu din istoria Loteriei Române....
[Ştirile ProTv] 20/04/2026
[Ştirile ProTv] 20/04/2026
Un bărbat a câștigat la loterie după ce a murit: cum a fost posibil și cine va încasa premiul de peste 700.000 de euro
O situație neobișnuită a pus pe jar autoritățile din Germania,...
[Adevarul] 20/04/2026
[Adevarul] 20/04/2026
Bărbat căutat de scafandri după ce a căzut din barcă într-o baltă
Un bărbat a căzut dintr-o barcă într-o baltă din satul...
[Gazeta de Sud] 20/04/2026
[Gazeta de Sud] 20/04/2026
Cine este câștigătorul celui mai mare premiu din istoria Loteriei Române. Premiul a fost ridicat
Cel mai mare premiu din istoria Loteriei Române a fost ridicat luni...
[StiripeSurse] 20/04/2026
[StiripeSurse] 20/04/2026
Bucureștean de 50 de ani bagă 13 MILIOANE DE EURO în buzunar! Cel mai mare JACKPOT din istoria Loteriei Române
Un bucureștean de 50 de ani câștigă 65 MILIOANE LEI la Joker –...
[Jurnalul National] 20/04/2026
[Jurnalul National] 20/04/2026
Cine este câștigătorul celui mai mare premiu din istoria Loteriei Române. A ridicat peste 12 milioane de euro
Cel mai mare premiu din istoria Loteriei Române a fost ridicat luni...
[Observator] 20/04/2026
[Observator] 20/04/2026
Cine este câștigătorul celui mai mare premiu din istoria Loteriei Române. Azi și-a ridicat banii
Cel mai mare premiu din istoria Loteriei Române, în valoare de peste...
[HotNews] 20/04/2026
[HotNews] 20/04/2026
Marele premiu la Joker a fost încasat: Cine este câștigătorul
Biletul norocos a fost jucat online, pe joaca.loto.ro şi a fost...
[Cotidianul] 20/04/2026
[Cotidianul] 20/04/2026
Rusia scoate la vânzare aur confiscat: vinde pentru 1,85 miliarde de dolari pachetul majoritar dintr-o companie minieră
Evaluarea a fost făcută de Rosimushchestvo, agenția guvernamentală...
[Mediafax] 20/04/2026
[Mediafax] 20/04/2026
S-a câştigat marele premiu la Joker, în valoare de aproape 13 milioane de euro
La tragerile loto din 19 aprilie 2026 s-a câștigat marele premiu la...
[Gazeta de Sud] 20/04/2026
[Gazeta de Sud] 20/04/2026
S-a câştigat cel mai mare premiu din istoria jocului Joker. Biletul la Loto a fost jucat online, cât a costat UPDATE
[Playtech] 20/04/2026
Performanţa în antreprenoriat nu este ca marele premiu câştigat la loto, ci ca medaliile cucerite în sport
[Business Magazin] 20/04/2026
Cel mai mare premiu din istoria loteriei a fost câștigat, în Ungaria: „Greutatea sumei în bancnote, cât a unui elefant”
Un jucător a câștigat, pe 18 aprilie, premiul-record pentru Ungaria...
[Libertatea] 20/04/2026
[Libertatea] 20/04/2026
S-a câștigat marele premiu la Joker, în valoare de 13 milioane de euro. Cât a costat biletul norocos
Zi extrem de norocoasă pentru un român! Marele premiu la Joker,...
[Cancan] 19/04/2026
[Cancan] 19/04/2026
S-a câștigat marele premiu la Joker, categoria I, în valoare de 13 milioane de euro, cu un bilet de 14,50 lei
S-a câştigat marele premiu la Joker, categoria I, în valoare de...
[Observator] 19/04/2026
[Observator] 19/04/2026
O nouă zi din viața lui Simeone
Atunci când o finală, un meci care se dispută cu un trofeu pe...
[Gazeta Sporturilor] 19/04/2026
[Gazeta Sporturilor] 19/04/2026
Rezultate LOTO, duminică, 19 aprilie. Reportul la Joker, categoria I, a ajuns la peste 12 milioane de euro
Duminică, 19 aprilie, au loc noi trageri Loto 6/49, Noroc, Joker,...
[Adevarul] 19/04/2026
[Adevarul] 19/04/2026
LOTO: Peste 12,80 milioane de euro report la extragerea Joker de duminică, 19 aprilie, 2026
LOTO.Duminică, 19 aprilie, 2026, au loc noi trageri Loto 6/49, Noroc,...
[DCNews] 19/04/2026
[DCNews] 19/04/2026
Un bărbat s-a vindecat de HIV după un transplant de celule stem de la fratele său: „Parcă am câștigat la loterie de două ori”
Un pacient cu HIV a spus că experiența prin care a trecut este „ca...
[HotNews] 18/04/2026
[HotNews] 18/04/2026
Procedură în premieră mondială. Un bărbat din Oslo s-a vindecat de HIV: „Parcă am câștigat la loterie de două ori”
Un pacient cu HIV a spus că se simte ca și cum ar fi „câștigat...
[Ştirile ProTv] 18/04/2026
[Ştirile ProTv] 18/04/2026
De ce este un casino online opțiunea mai bună pentru jucătorii începători
Pentru cei care sunt la început în lumea jocurilor de noroc poate...
[Gazeta de Sud] 17/04/2026
[Gazeta de Sud] 17/04/2026
Rezultatele la LOTO. Numerele extrase joi la Loto 6/49, Noroc, Joker și Loto 5/40. Report de aproape 13 milioane euro la Joker
Joi, 16 aprilie 2026, au avut loc noi trageri Loto 6/49, Noroc, Joker,...
[HotNews] 16/04/2026
[HotNews] 16/04/2026
Trei hoți, bătuți de locatarii apartamentului pe care au vrut să-l jefuiască
Trei bărbați au fost reținuți pentru tâlhărie, după ce ar fi...
[Gazeta de Sud] 16/04/2026
[Gazeta de Sud] 16/04/2026
LOTO: Peste 12,68 milioane de euro report la extragerea Joker de joi, 16 aprilie, 2026
LOTO. Joi, 16 aprilie, 2026, au loc noi trageri Loto 6/49, Noroc,...
[DCNews] 16/04/2026
[DCNews] 16/04/2026
85.000 de euro, pulverizaţi pe un sistem de arteziene în Parcul Romanescu
Până la finalul Târgului de Paşte organizat în Parcul Romanescu,...
[Gazeta de Sud] 16/04/2026
[Gazeta de Sud] 16/04/2026
Barclays recomandă clientilor să vândă titlurile de stat ale României si să cumpere titlurile de stat ale Ungariei
Uraa !!Am vazut oameni care se bucura ca s-a schimbat Guvernul din...
[Info Brașov] 15/04/2026
[Info Brașov] 15/04/2026
HIV/ Un pacient a intrat în remisie după un transplant de măduvă împotriva unui tip de cancer de sânge
Un pacient norvegian, infectat cu HIV, se află în prezent în...
[Ecopolitic] 15/04/2026
[Ecopolitic] 15/04/2026
Un bărbat infectat cu HIV s-a vindecat complet datorită unei mutații genetice rare
Un bărbat din Norvegia, HIV-pozitiv din 2006 și diagnosticat cu...
[Descopera] 15/04/2026
[Descopera] 15/04/2026
ZIARE . REVISTE
loto
TEME DIVERSE
-
Animale
Anunţuri
Artă & Cultură
Auto-moto
Bucatarie
Cinema
Copii şi părinţi
Diaspora
Divertisment
Educatie
Femei & fete
Finanţe Afaceri
Foto
Imobiliare
Informatica
Jocuri video
Meteo
Mondene
Muzica
Politica, Istorie
Profesionale
Publicitate
Radio
Sanatate
Satira & Umor
Spiritualitate
Stiinţă, Tehnică
Turism Natură
| Adăugarea sau scoaterea conținutului dvs | Contact
|
ZIAR.COM : știri libere | știri tv live și știri de ultima oră
Ziar.com indexează publicații diverse, ziare și reviste cu poziții diferite, existente independent online. Ideile și comentariile exprimate în aceste articole nu reflectează opiniile Ziar.com și nu pot fi imputate acestuia. Pentru orice informație complementară sau reclamație cu privire la conținut, consultați direct ziarele relevante – sursa este întotdeauna indicată, cu un link spre articolul de origină.
Publicare, realizare si gazduire web : DIRECTWAY. Toate drepturile rezervate, reproducerea interzisa - Copyright © 1996-2026 DIRECTWAY